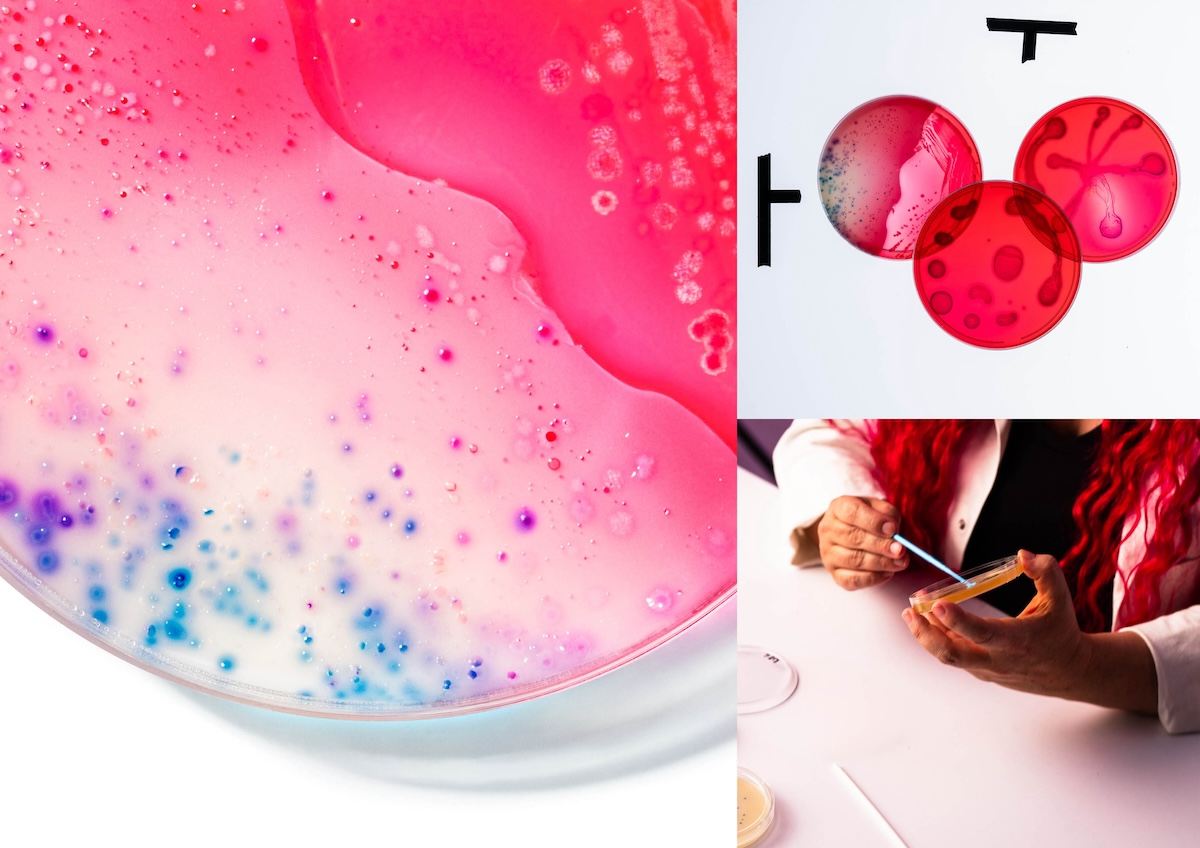

No Ugly transforms inner gut beauty into works of art in new campaign via Droga5 Aotearoa

New Zealand wellness brand No Ugly is showing Kiwis that beauty starts on the inside by turning the science of gut health into a literal work of art in its latest campaign to promote tonic range ‘No Ugly Gut’ and how it supports inner gut beauty.
Created by Droga5 Aotearoa, part of Accenture Song, ‘The Bacteria That Grew a Campaign’ dials up the science credentials of No Ugly Gut in a uniquely artistic way by putting bacteria under the microscope to demonstrate the beauty of ‘good’ bacteria in your gut.
The campaign includes OOH, press and social, and is supported by a ‘making of’ film that talks to how the agency cultivated the bacteria for the purposes of the photo shoot.

To create the campaign visuals, Droga5 Aotearoa used agar plates as a canvas to cultivate bacterial growth. Using the real bacteria in No Ugly Gut, Bacillus coagulans, the team was able to bring out the beauty of the growth patterns to create the artworks.
Working with leading microbiologist Dr Siouxsie Wiles, the team designed the bacterial growth to reflect the beauty of a thriving microbiome, demonstrating the natural beauty that exists inside when your gut is at its best.
Dr Siouxsie Wiles says: “One of the things I like about doing these kinds of art projects is that when people hear the word bacteria, they often think of pandemics and disease. However, there are lots and lots of species of bacteria, and many of them are really good — many we couldn’t live without. I love that we can take something invisible and make it visible, to show just how beautiful bacteria can be.”
No Ugly director and co-founder Aaron Taylor says: “Our Gut tonic helps balance your microbiome, clearing out the bad bacteria so the good bacteria can thrive. Therefore, the purpose of our new work is to dial up our science credentials, whilst also demonstrating how beautiful ‘good’ bacteria in your gut can be. It’s all part of our mission to rid the wellness world from ugly.”
Droga5 Aotearoa chief creative officer Damon Stapleton adds: “No Ugly has always been about real health as opposed to some of the more extreme practices and values of the wellness industry. One of them being the obsession with external beauty. This campaign counters that thinking by showing that inner beauty is far more important by turning inner gut health into a literal work of art.”
Watch the making of film below:
Client: No Ugly
Director / Co-Founder: Aaron Taylor
General Manager: Sara Eichmann
Creative Agency: Droga5 Aotearoa, part of Accenture Song
Chief Executive Officer: Storm Day
Chief Creative Officer: Damon Stapleton
Associate Creative Director: Liz Richards
Associate Creative Director: Nick Dellabarca
Art Director: Zac Nairn
Copywriter: Casey Clarke
Creative Services Manager: Emma Smyth
General Manager / Head of Integrated Production: Rosie Grayson
Producer: Callum Crabb
Design Lead: Lucinda Fortescue-Hansen
Designer: Vivian Heng
Finished Artist: Lisa Stowers
Group Business Director: James Allan
Business Manager: Lily Tootill
Photographer: Victoria Baldwin
DoP: Fergus Cahill
Assistant: Anton Mauer
Retouching: Sixty Four Ltd – Scott Nadin